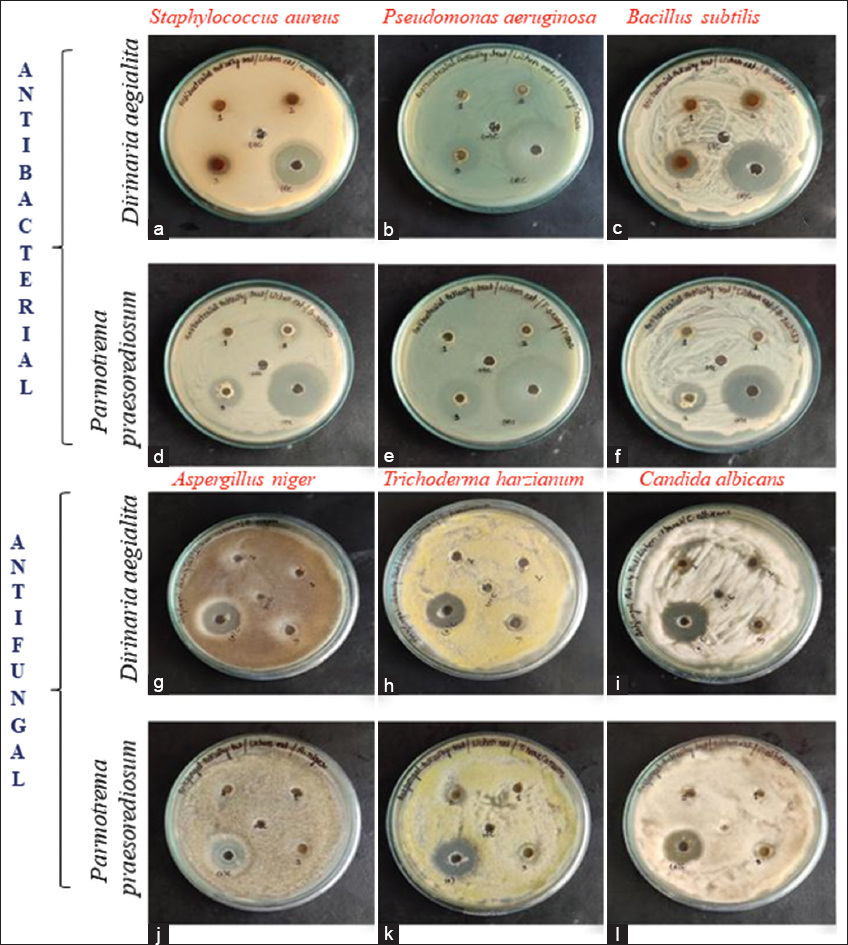

1. INTRODUCTION
In recent years, the study on bioactivity and production of pharmaceutically important products from lichens is receiving considerable attention. Lichens are composite structure composed of algae (photobiont) and fungi (mycobiont). However, the structural composition of lichens is dominated by fungus, which ultimately control the symbiosis; hence, lichens are called as lichenized fungi. It is a great source of bioactive secondary metabolites [1]. Approximately 20000 species of lichen have been recorded so far globally, which inhabits over 10% of the terrestrial surface [2,3]. Lichens have been used as foods, medicines, cosmetics, and other ethnobotanical reasons in modern facts from prehistoric to recent days [4]. Because lichens produce secondary metabolites, they adapt to cosmopolitan distribution [5-7] and show antimicrobial, antiviral, anticancer, antioxidant, and antidiabetic activity [8-10]. The Similipal Biosphere Reserve is well known for its lichen diversity [11-14]. However, this region has not been explored enough to find out the potential bioactive compound in lichens and their pharmaceutical values [15].
Dirinaria aegialita (Afzel. ex Ach.) B. J. Moore and Parmotrema praesorediosum (Nyl.) Hale are two macro-lichens belongs to the Caliciaceae and Parmeliaceae family, respectively. Both the foliose species grow luxuriantly on a number of trees and rocks in Similipal Biosphere Reserve. The lichen genus Dirinaria has 25 species worldwide, which produce divaricatic acid and sikikaik acid and triterpenoids as their major secondary metabolites. The pharmaceutical importance of different species of Dirinaria is so far known for its antioxidant, antimicrobial, cytotoxic, anti-inflammatory, insecticidal, and larvicidal activity [16-22]. However, D. aegialita is evaluated only for its antifungal activity [23].
Parmotrema praesorediosum belongs to the genus Parmotrema, comprises 300 species, and considered as one of the largest genera of the family – Parmeliaceae [24]. Parmotrema is used as spices [25], in silk dyeing [26] and source for many bioactive compounds [27], and praesorethers E, F, and G, g-lactonic acids, Vinapraesorediosic acid D and E [28-30], which have potential cytotoxicity activity and successfully investigated against different human cancer cell lines [31] and known for its anti-arthritic potential [32]. The presence of aliphatic acids (protopraesorediosic) makes it significant to use in synthesis of silver nanoparticles (AgNPs) to inhibit the growth of pathogenic organisms [33,34]. In view of the above, the present study was conducted with an objective to evaluate the antimicrobial, antioxidant, and anticancer activities of macro-lichen found in Similipal Biosphere Reserve of Odisha [Figure 1].
 | Figure 1: Schematic representation for evaluation of pharmaceutical potential of Dirinaria aegialita and Parmotrema praesorediosum. [Click here to view] |
2. MATERIALS AND METHODS
2.1. Sample Collection
Fresh lichen samples (Parmotrema praesorediosum and Dirinaria aegialita) were collected from Similipal Biosphere Reserve in Mayurbhanj district of Odisha [Figure 2]. The Similipal Biosphere Reserve of Mayurbhanj district is in North-east Odisha lying between 21°28’ to 22°08’ N and 86°04, to 86°37’ E. It is covered with dense forested hills and valleys and dry deciduous vegetation occupying 5569 km2 area which is almost half of the geographical area of Mayurbhanj district. On an average, the area receives 1800 mm annual rain fall with temperature ranging from 3°C to 38°C.
 | Figure 2: Lichen samples collected from the study site. [Click here to view] |
2.2. Lichen Identification
The collected specimens were identified according to their morphology, anatomy, and chemistry [35]. The color tests were carried out with aqueous potassium hydroxide (K), Steiner’s stable paraphenylenediamine (PD), and aqueous calcium hypochlorite (C). The identified samples of D. aegialita and P. praesorediosum deposited in the lichen herbarium of CSIR-National Botanical Research Institute, Lucknow (LWG) with accession number CUTM-159 and CUTM-184, respectively.
2.3. Preparation of Lichen Extract
To prepare lichen extract, the collected samples (10 mg) were added with 100ml methanol and incubated at room temperature with intermittent mixing. Then, the extract was filtered using Whatman number-1 filter paper. The solvent was allowed to evaporate from filtrate till the extract become completely dry, finally remaining residue was collected as the lichen extract. The extract obtained was stored at 4°C for further use and this extract was used to prepare five different concentrations, that is, 0.1 mg/ml, 0.2 mg/ml, and 0.3 mg/ml in methanol for the antimicrobial screening test.
2.4. Qualitative and Quantitative Phytochemical Analysis
The qualitative and quantitative study of phytochemical was carried out by preparing lichen extract in water, methanol, hexane, chloroform, and 2-propanol with the help of biochemical and UV-Vis spectrophotometry method, respectively [36-40]. Major characteristics of all the solvents are provided in Table 1, Figures 3 and 4.
Table 1: Quantitative phytochemical screening of the collected samples in different solvents.
| Lichens sp. | Phytochemical constituents mg/g | Concentration of phytochemical in mg/g of lichen extract | ||||
|---|---|---|---|---|---|---|
| Aqueous | Methanol | Hexane | Chloroform | 2-Propanol | ||
| Dirinaria aegialita | Alkaloids | 5.51±0.05 | 8.84±0.03 | 6.87±0.08 | 4.86±0.04 | 5.41±0.06 |
| Flavonoids | 3.41±0.09 | 4.48±0.03 | 3.34±0.04 | 2.41±0.03 | 3.74±0.03 | |
| Total Saponins | 1.51±0.04 | 1.23±0.04 | 1.11±0.07 | 1.21±0.03 | 2.31±0.06 | |
| Steroids | 2.55±0.08 | 3.42±0.04 | 2.55±0.07 | 3.26±0.04 | 2.84±0.03 | |
| Tannins | 2.54±0.03 | 3.57±0.08 | 3.51±0.05 | 3.36±0.04 | 2.51±0.05 | |
| Terpenoids | 1.59±0.05 | 1.51±0.07 | 1.35±0.05 | 2.31±0.05 | 3.75±0.02 | |
| Parmotrema praesorediosum | Alkaloids | 6.41±0.06 | 9.44±0.03 | 6.97±0.07 | 5.66±0.04 | 6.41±0.07 |
| Flavonoids | 5.41±0.09 | 7.48±0.03 | 4.44±0.05 | 3.71±0.08 | 4.44±0.03 | |
| Saponins | 3.51±0.04 | 0.58±0.04 | 0.71±0.07 | 1.21±0.03 | 1.37±0.05 | |
| Steroids | 3.45±0.09 | 5.42±0.05 | 3.55±0.03 | 4.26±0.04 | 3.74±0.04 | |
| Tannins | 1.57±0.03 | 2.57±0.05 | 2.41±0.05 | 4.56±0.06 | 3.51±0.08 | |
| Terpenoids | 2.55±0.04 | 2.41±0.06 | 1.45±0.06 | 3.35±0.07 | 2.65±0.05 | |
 | Figure 3: Quantitative screening of phytochemical in different solvent system of Dirinaria aegialita. [Click here to view] |
 | Figure 4: Quantitative screening of phytochemical in different solvent system of Parmotrema praesorediosum. [Click here to view] |
2.5. Microorganisms and Chemicals
Three strains of bacteria [Staphylococcus aureus (MTCC-96), Pseudomonas aeruginosa (MTCC-424), and Bacillus subtilis (MTCC-441)] and three strains of fungi [Aspergillus niger (MTCC-282), Trichoderma harzianum (MTCC-3178), and Candida albicans (MTCC-183)] were used for antimicrobial screening. The microorganisms were procured from IMTECH Chandigarh and maintained in Department of Botany, Centurion University of Technology and Management, Odisha.
2.6. Determination of Antimicrobial Potential
The antimicrobial potential was evaluated by agar well diffusion method [41]. For bacterial culture, the Muller Hinton agar media was prepared by suspending 38 g of the media in 1L water, while for fungal culture Sabouraud dextrose agar media prepared by draping 65 g of media in 1L water and autoclaved at 121°C with 15 psi for 15min. After sterilization, the media was poured into sterile glass petri-dishes followed by inoculation of 100μl of the culture broth and allowed for incubation at 37°C for 24 h.
2.7. Minimum Inhibitory Concentration (MIC)
The conventional 96 well plates with Mueller–Hinton broth (MHB) were used to determine the MIC. The different concentrations of lichen extracts, as well as MHB and pathogen as controls, were made using two-fold serial dilution. A total of 50 μg of the test bacterial inoculum with 105 colony forming unit/ml concentration was added [42]. After 24 and 48 h, the samples were tested for bacteria using a microplate reader (Bio-Rad, iMark-11457) at 595 nm. The MIC value was calculated as the lowest concentration of extract in the broth medium that inhibits the growth of the pathogens being examined [43].
2.8. Cell Culture and Reagents
For cell culture, all the chemical reagents and media used were procured from Invitrogen. MCF-7 and MDA-MB-231 breast cancer cell lines were obtained from the cell repository of the National Center for Cell Science, Pune, Maharashtra, India.
2.9. Antioxidant activity by 2, 2-Diphenyl-1-picrylhydrazyl) Radical Scavenging Assay (DPPH)
Different aliquots of standard, that is, ascorbic acid (1mg/ml) with methanol extracts of plant ranges from (6.25 to 200 μg/ml) were taken and the total volume was adjusted to 250 μl with methanol [44]. 1 ml of DPPH at a concentration of 4mg/100ml was added to the extract and the tube was kept in dark condition at room temperature for 30 min. The absorbance was taken against the blank at 517 nm, % of free radical scavenging was calculated based on the extent of reduction in the color.
% of radical scavenging activity= Ac-As/Ac ×100, Where Ac=Absorbance of control, As= Absorbance of sample.
2.10. Anticancer Evaluation Using MCF-7 and MDA MB-231 Breast Cell Lines
The anticancer evaluation assay was performed using two human breast cancer cell lines, MCF7 and MDA MB-231. In brief, cells were allowed to grow in culture medium (MEM, DMEM) supplemented with 10% FBS, 1% penicillin/streptomycin, with maintenance of temperature at 37°C and 5% CO2. In a 96-well plate, cancer cells were seeded at a density of 4 × 103 cells/well, then treated with increasing concentrations from (6.25 to 100 μg/ml) of methanolic extract of lichens, for 72 h. The cells were then stained with 0.56% of Sulforhodamine B in 1% acetic acid. To remove unbound stains by washing, 1% acetic acid was used. 10 mM Tris base with 10.5 pH was added to the 96 well plate containing fixed cells with protein bound stain and the absorbance was taken at 495 nm wavelength using a Bio Rad 96 well plate reader [45]. The IC50 values for the extract were calculated from the plate reader data using an online IC50 value calculator (AAT Bioquest, Inc., Sunnyvale, CA, USA).
2.10.1. DAPI staining for detection of apoptosis
Apoptotic cells were visualized by DAPI staining method with fluorescence microscopy. MCF-7 cells were grown on 6-well plates and were treated with the methanolic extracts of Dirinaria aegialita and Parmotrema praesorediosum at IC50 concentration for 72 h. After incubation, 6-well plates were fixed in 3% formaldehyde and washed with PBS, stained with DAPI having a concentration of 1mg/ml, and washed after 5 min using 1× PBS to remove unbound stain. Images were captured using a fluorescent microscope (Nikon Eclipse Ts2R-FL). Apoptotic cells were identified based on morphology of cells, for example, nuclear condensation, formation of membrane blebs and apoptotic bodies, etc. compared to untreated cells [46].
2.10.2. Ethidium bromide for detection of apoptosis
Apoptotic cells were visualized by ethidium bromide staining method with fluorescence microscopy. MCF-7 cells were grown on 6-well plates and were treated with the methanolic extracts of D. aegialita and P. praesorediosum, at IC50 concentration for 72h. After incubation, 6-well plates were fixed in 3% formaldehyde and washed with PBS, stained with EtBr having a concentration of 3mg/ml, and washed after 5 min using PBS to remove unbound stain. Images were captured using a fluorescent microscope (Nikon Eclipse Ts2R-FL). Apoptotic cells were identified based on stains taken by the cells. The cells stained with red represent both live and pre-apoptotic cells which are stained with EtBr displayed membrane blabbing forming apoptotic bodies as well as nuclear condensation [47].
2.11. Statistical Analysis
The results of the experiment were statistically examined. All of the experiments were done in triplicates, and the results were expressed as mean values with standard deviations (±SD).
3. RESULTS
3.1. Phytochemical’s Analysis
In quantitative screening, the methanolic extract of both the species exhibited presence of alkaloid, flavonoid, steroid, and together with tannins and triterpenoids. Saponins were observed in aqueous extract of D. aegialita only. Steroids were found in methanolic extract of both species as well as chloroform and 2-propanol extract of D. aegialita. Flavonoids together with steroids were reported in methanol, chloroform, and 2-propanol extract of D. aegialita, while triterpenoids exhibited their presence in all extract of both the species. Hexane, chloroform, and 2-propanol extract of P. praesorediosum exhibit presence of alkaloids, flavonoids, tannins, and triterpenoids. Glycosides were found in methanolic and aqueous extract of both the species. Tannins were absent in chloroform and hexane extract of D. aegialita and P. praesorediosum, respectively, while present in all other solvent extracts.
The quantitative phytochemical analysis is also correlated to the qualitative data of phytochemicals [Table 1], which confirmed the presence of maximum phytochemicals in the methanolic extract [Figures 3 and 4]. In particular, the methanolic extract of both the species of lichen exhibited maximum presence of alkaloids, flavonoids, steroids, and tannins. Saponin found to be highest in 2-propanol and water in case of D. aegialita and P. praesorediosum, respectively. Similarly, terpenoids present highest in 2-propanol and chloroform in case of D. aegialita and P. praesorediosum.
3.2. Antioxidant Assay
The scavenging activity of lichen extract against DPPH radical is depicted in Figure 5, which shows that there is a significant correlation between the extract studied and the positive control (r>0.7). The antioxidant activity was increased from 32.2 to 93.1 with the increase in concentration of D. aegialita extract from 6.25 μg/ml to 150 μg/ml. Similarly, antioxidant activity of P. praesorediosum was increased from 21.8 to 86.4 with the increase in concentration from 6.25μg/ml to 150μg/ml. Among all the extract taken the methanolic, one showed highest scavenging activity against DPPH radical: 93.1 and 86.4 at 150μg/ml extract of D. aegialita and P. praesorediosum, respectively.
 | Figure 5: DPPH assay of Dirinaria aegialita and Parmotrema praesorediosum. [Click here to view] |
3.3. Antimicrobial Assay
It is revealed from the present study that P. praesorediosum had a pronounced activity against the microbes as compared to D. aegialita [Table 2 and Figure 6]. In case of P. praesorediosum, the most susceptible bacterium is Staphylococcus aureus which recorded a highest inhibition of 17±0.82 mm at concentration 0.3 mg/ml, compared to D. aegialita, showing 15±0.78 mm inhibition against Bacillus subtilis at concentration 0.3 mg/ml, as well as at low concentration, which recorded 10±0.75 mm zone of inhibition at concentration of 0.2 mg/ml [Figures 7 and 8]. P. praesorediosum has well inhibitory zone at low concentration for all the pathogen taken except A. niger and C. albicans. However, P. praesorediosum showed high antifungal activity against T. harzianum, with 13 ± 0.77 mm zone of inhibition at concentration of 0.3 mg/ml, while D. aegialita showed high antifungal activity against C. albicans, with 13 ± 0.74 mm of inhibition at 0.3 mg/ml. When compared with the antibacterial drug ciprofloxacin and antifungal drug luliconazole, it was found that P. praesorediosum had better efficacy against S. aureus as compared to ciprofloxacin.
Table 2: The zone of inhibition (mm) obtained for the lichen extract against the bacterial and fungal isolates. DA- Dirinaria aegialita, PP- Parmotrema praesorediosum. (+) C -Positive control, (-) C -Negative control [values are expressed as mean±SD in triplicates].
| Organism | Zone of Inhibition (mm) | |||||||||
|---|---|---|---|---|---|---|---|---|---|---|
| 0.1 mg/ml | 0.2 mg/ml | 0.3 mg/ml | (+) C | (-) C | ||||||
| DA | PP | DA | PP | DA | PP | DA | PP | DA | PP | |
| Staphylococcus aureus | Nil | Nil | Nil | 12±0.81 | 13±0.73 | 17±0.82 | 23±0.75 | 25±0.76 | - | - |
| Pseudomonas aeruginosa | Nil | Nil | Nil | 13±0.74 | 13±0.76 | 17±0.78 | 32±0.79 | 33±0.77 | - | - |
| Bacillus subtilis | Nil | Nil | 10±0.75 | 11±0.77 | 15±0.78 | 16±0.80 | 28±0.81 | 29±0.75 | - | - |
| Aspergillus niger | Nil | Nil | Nil | Nil | 12±0.71 | 12±0.75 | 18±0.78 | 19±0.74 | - | - |
| Trichoderma harzianum | Nil | Nil | Nil | 10±0.75 | 10±0.72 | 13±0.77 | 18±0.76 | 20±0.73 | - | - |
| Candida albicans | Nil | Nil | Nil | Nil | 13±0.74 | 11±0.75 | 20±0.78 | 19±0.77 | - | - |
The zone of inhibition (mm) obtained for the lichen extract against the bacterial and fungal isolates. DA- Dirinaria aegialita, PP- Parmotrema praesorediosum. (+) C -Positive control, (-) C -Negative control [values are expressed as mean±SD in triplicates].
| Figure 6: (a-f) Respective antimicrobial activity of Dirinaria aegialita and Parmotrema praesorediosum extract against the bacterial pathogen Staphylococcus aureus, Pseudomonas aeruginosa and Bacillus subtilis. (g-l) Respective antifungal activity of Dirinaria aegialita and Parmotrema praesorediosum extract against fungal isolates Aspergillus niger, Trichoderma harzianum and Candida albicans. [Click here to view] |
 | Figure 7: Activity of Dirinaria aegialita extract against different pathogens. [Click here to view] |
 | Figure 8: Activity of Parmotrema praesorediosum extract against different pathogens. [Click here to view] |
3.4. Minimum Inhibitory Concentration (MIC)
Anti-microbial properties of both the lichen species against the selected pathogens were evaluated by their MIC values [Table 3]. The antimicrobial activities of the lichen extracts were identified against the test pathogens. Among the test bacteria and fungus, the MIC ranged from 185 to 290 μg/ml.
Table 3: MIC of methanolic extract of D. aegialita and P. praesorediosum.
| Strains | MIC (mg/ml) | |
|---|---|---|
| Methanol | ||
| Dirinaria aegialita | Parmotrema praesorediosum | |
| Staphylococcus aureus | 290 | 195 |
| Pseudomonas aeruginosa | 285 | 185 |
| Bacillus subtilis | 190 | 185 |
| Aspergillus niger | 280 | 275 |
| Trichoderma harzianum | 275 | 185 |
| Candida albicans | 245 | 275 |
3.5. Anticancer Potential
The activity of two macro lichens against MCF-7 breast cancer cell line as evident during the present study is depicted in Figure 9a, which revealed that D. aegialita had higher anticancer activity against the breast cancer cell line with IC50 value of 48.1±1.5 μg/ml, while IC50 value for P. praesorediosum extract is around 67.5±0.6 μg/ml. D. aegialita showed higher anticancer activity against MDA MB-231 breast cancer cell line [Figure 9b] with IC50 value of 86.1±1.4 μg/ml, whereas the IC50 value for P. praesorediosum extract is around 125±1.2 μg/ml [Table 4].
 | Figure 9: Activity of Dirinaria aegialita and Parmotrema praesorediosum extract against MCF-9 (a) and MDAMB-231 (b) breast cancer cell line. [Click here to view] |
Table 4: IC50 values of methanolic extract of Lichens-1 and 2 using two human breast adenocarcinoma cell lines, MCF-7 and MDAMB-231. Both the extracts were found to have anti proliferative activity compared to untreated one.
| IC50 (mg/ml) | Dirinaria aegialita | Parmotrema praesorediosum |
|---|---|---|
| MCF-7 | 48.1±1.5 | 67.5±0.6 |
| MDA-MB-231 | 86.1±1.4 | 125±1.2 |
Figures 10a and b panels show morphological features of MCF-7 cells stained with DAPI (4’,6-Diamidino-2-phenylindole dihydrochloride), EtBr (Ethidium Bromide), from untreated cells (upper panels), and cells treated with IC50 concentration of methanolic extract of P. praesorediosum and D. aegialita, respectively, (lower panels) for 72 h using fluorescence microscopy. The apoptotic cancer cells were identified by morphology of treated cells, that is, membrane contraction, nuclear condensation, and fragmentation, etc. after 72 h of drug treatment to the cancer cell line.
 | Figure 10: DAPI (a) and ethidium bromide (b) staining to morphologically detect apoptosis in MCF-7 cell line. [Click here to view] |
4. DISCUSSION
The screening of phytochemicals for their antimicrobial, antioxidant, and anticancer properties was carried out using the extract of two different lichens from Similipal Biosphere Reserve, Odisha. The results of the investigation revealed the presence of diverse constituents with significant pharmacological and biological properties [48,49]. The phytochemical analysis confirmed the presence of alkaloids, flavonoids, saponins, steroids, tannins, and triterpenoids in the test lichen extracts. Phenolics are the most abundant and diverse group of plant metabolites, with anticancer, antibacterial, anti-inflammatory, and antioxidant properties, as well as effective in cardiovascular and neurodegenerative diseases [50-52]. The presence of flavonoids and tannins, which belongs to phenolics class of compounds, adds the bioactivity of the lichen species under studied [53,54]. The lichen extract also contains saponin, which are having importance for their anti-inflammatory, anti-microbial, anti-tumor, and anti-ulcer activities [55-57]. Steroid also has been reported for its antimicrobial activity [58]. The presence of alkaloids also adds the pharmacological activities of the plants as analgesics, anticancer, anti-inflammatory, and antimicrobial activity [59]. Maximum number of phytochemicals extracted in methanolic extract of the selected lichen, similar to the other findings [60-64].
The methanolic extract of D. aegialita and P. praesorediosum showed 93.1% and 86.4% scavenging activity, respectively, at concentration 150 mg/ml, resonating to the earlier studies [65-67]. Among both the species, D. aegialita showed better scavenging potential as compared to P. praesorediosum. The presence of flavonoids in both species is correlated by their antioxidant potential, which supports the findings of other studies [68-71].
During the present investigation, antimicrobial activity of the methanolic extract of D. aegialita and P. praesorediosum was examined against six pathogens, since methanol is responsible for maximum extraction of phenolics and flavonoids compounds, thereby yielding maximum antimicrobial activity [72,73]. The findings showed that the test lichen extracts possessed very strong antibacterial activities as compared to antifungal activity. The Gram-positive bacteria were observed to be more susceptible toward the lichen extract taken, as compared to the Gram-negative strain, although they possess thick cell wall. The less sensitivity of Gram-negative bacteria can be explained by the presence of additional membrane with appendices and several pores, which makes them resistant to antibiotics [74]. The growth of microorganism is inhibited by their mechanism of enzyme action. This inhibitory mechanism may be carried out by the reaction between oxidizing compounds and the functional groups of proteins, alternatively this leads to the phenolics toxicity [75]. Antimicrobial compounds tested in vitro have been proven to be effective against a wide range of bacteria. This action is likely due to their capacity to form complexes with extracellular and soluble proteins, as well as with bacteria’s cell walls, resulting in protein inactivation and function loss [76]. Microbial membranes may also be disrupted by more lipophilic flavonoids [77]. As a result, the potential of flavonoids as an antibacterial agent is interesting. Among the lichen species under the study, P. praesorediosum was found to have more antimicrobial activity than that of D. aegialita against all the pathogen tested. This finding was in line with another study that found that extracts of acetone, methanol, petroleum ether, and diethyl ether from three species of foliose lichen, Dirinaria picta, Dirinaria papillulifera, and Dirinaria applanata, had antimicrobial activity against human pathogenic bacteria and fungi using a well-diffusion method against human pathogenic bacteria and fungi [78,79]. Earlier reports also indicated that extracts of P. praesorediosum in methanol, acetone, hexane, and dichloromethane have inhibitory action against bacterial and fungal diseases [80].
Cancer is a public health problem in both developing and developed countries. Despite new scientific advancements, cancer claimed the lives of approximately 9.6 million people in 2018 [81]. Because of the negative side effects of chemotherapy and radiation therapy, scientists have turned to natural compounds as an alternative. Lichens have recently claimed an increasing interest in medication research because they are a symbiotic partnership of algae and fungus that produce a variety of secondary compounds. For ages, lichens have been utilized by the conventional healers [82,83]; however, there are just a few anticancer reports accessible. This is the first anticancer report of D. aegialita against the breast cancer cell line. The anticancer activity of D. aegialita is more significant than that of P. praesorediosum, which can be correlated to its antioxidant activity toward free radical similar to the studies on Dirinaria consimilis [84]. The apoptotic process was visualized through binding of ethidium bromide and DAPI to the damaged cell.
5. CONCLUSION AND FUTURE PROSPECTIVE
Among both the lichen species, P. praesorediosum showed higher antimicrobial activity, while D. aegialita showed higher antioxidant potential together with higher anticancer activity. The Dirinaria aegialita also shows more effectiveness than that of Parmotrema praesorediosum, in the preliminary investigation in terms of cell line study. The study suggests further investigation to identify the compounds and their mechanism of action toward cancer cell lines and against pathogenic strain of microorganisms for the future clinical perspective to counter cancer as well as infectious pathogenic disease. Both the species studied for their antimicrobial, antioxidant, and anticancer properties grow luxuriantly in tropical and lower temperate regions of India. As evident from the preliminary biological screening studies, both the species were observed to have good pharmaceutical potential and need further intensive investigation to identify the potent bioactive molecule for development of phytochemical for human welfare.
6. ACKNOWLEDGMENT
The authors would like to thank and acknowledge the Center for Excellence in Natural Products and Therapeutics, Department of Biotechnology and Bioinformatics, Sambalpur University and CSIR-National Botanical Research Institute, Lucknow for the necessary laboratory facilities.
7. AUTHORS’ CONTRIBUTIONS
SP and RKM had conceptualized the idea, worked and prepared the data, and results along with the draft manuscript and RKM, DKU, and KBS have edited final draft manuscript. All authored have written, reviewed, and edited the manuscript.
8. FUNDING
There is no funding to report.
9. CONFLICTS OF INTEREST
All authors have read the Journal’s policy on authorship agreement and disclosure of potential conflicts of interest. They have none to declare.
10. ETHICAL APPROVALS
This study does not involve experiments on animal and human subjects.
11. DATA AVAILABILITY
The authors confirmed that all the relevant data are included in the article.
12. PUBLISHER’S NOTE
This journal remains neutral with regard to jurisdictional claims in published institutional affiliation.
REFERENCES
1. Rankovi?B, Kosani?M. Lichens as a potential source of bioactive secondary metabolites. In:Lichen Secondary Metabolites. Cham:Springer;2019. 1-29. [CrossRef]
2. Martellos S, d'Agostino M, Chiarucci A, Nimis PL, Nascimbene J. Lichen distribution patterns in the ecoregions of Italy. Diversity 2020;12:294. [CrossRef]
3. Lücking R, Hodkinson BP, Leavitt SD. Corrections and amendments to the 2016 classification of lichenized fungi in the Ascomycota and Basidiomycota. Bryologist 2017;120:58-69. [CrossRef]
4. Sutar RR, Gaikwad SB, Mapari SV, Behera BC. Lichens:Traditional use and biological activities. Bot Pac 2021;10:69-82. [CrossRef]
5. Shukla V, Patel DK, Bajpai R, Semwal M, Upreti DK. Ecological implication of variation in the secondary metabolites in parmelioid lichens with respect to altitude. Environ Sci Pollut Res Int 2016;23:1391-7. [CrossRef]
6. Goga M, Ele?ko J, Marcin?inováM, Ru?ováD, Ba?korováM, Ba?kor M. Lichen metabolites:An overview of some secondary metabolites and their biological potential. In:Co-Evolution Secondary Metabolites. Berlin:Springer;2020. 175-209. [CrossRef]
7. Calcott MJ, Ackerley DF, Knight A, Keyzers RA, Owen JG. Secondary metabolism in the lichen symbiosis. Chem Soc Rev 2018;47:1730-60. [CrossRef]
8. Shahid M, Rasool A, Anjum F, Rehman MT. Biomedical perspectives of lichen?derived products. In:Lichen?derived products:Extraction Applications. Hoboken, New Jersey:Wiley;2020. 263-76. [CrossRef]
9. Thadhani VM, Karunaratne V. Potential of lichen compounds as antidiabetic agents with antioxidative properties:A review. Oxid Med Cell Longev 2017;2017:2079697. [CrossRef]
10. Oh JM, Kim YJ, Gang HS, Han J, Ha HH, Kim H. Antimicrobial activity of divaricatic acid isolated from the lichen Evernia mesomorpha against methicillin-resistant Staphylococcus aureus. Molecules 2018;23:3068. [CrossRef]
11. Nayak SK, Bajpai R, Upreti DK, Satapathy KB. Diversity of lichen flora of Odisha, India a review. Study Fungi 2016;1:114-24. [CrossRef]
12. Pradhan S, Upreti DK, Satapathy KB. Diversity, distribution and abundance of lichen in similipal biosphere reserve, Odisha. J Exp Biol Agric Sci 2021;9:781-90. [CrossRef]
13. Pradhan S, Upreti DK, Satapathy KB. Lichen diversity on Shorea robusta Gaertn. in the transitional zone of similipal biosphere reserve. Ambient Sci 2021;8:74-8. [CrossRef]
14. Pradhan S, Satapathy KB. A study on diversity of lichen in the north-west transitional zone of Mayurbhanj district of Odisha, India. Indian J Nat Sci 2020;10:26985-90.
15. Sahoo B, Dash S, Parida S, Sahu JK, Rath B. Antimicrobial activity of the lichens Parmotrema andium and Dirinaria applanata. J App Biol Biotechnol 2021;9:93-7.
16. Thangjam NM, Kumar A, Laldingliani T, Upreti DK. New distributional records of lichens for the state of Mizoram, Indo-Burma region of India. Trends Sci 2022;19:1-14. [CrossRef]
17. Kekuda TP, Dhanya R, Dhatri R, Sunita CM, Onkarappa R, Vinayaka KS. Radical scavenging, antimicrobial and insecticidal efficacy of Parmotrema cristiferum and Dirinaria applanata. Sci Technol Arts Res J 2015;4:95-102. [CrossRef]
18. Afieroho OE, Noundou X, Krause RW, Isaacs M, Olley L, Hoppe HC, et al. An antiplasmodial depside from a Nigerian lichen Dirinaria picta, epiphytic on the oil palm Elaeis guineense. Rev Bol Quím 2018;35:31-9.
19. Ahmed E, Elkhateeb W, Taie H, Rateb M, Fayad W. Biological capacity and chemical composition of secondary metabolites from representatives'Japanese lichens. J Appl Pharm Sci 2017;7:98-103. [CrossRef]
20. Tatipamula VB, Vedula GS. In vitro anti-inflammatory and cytotoxicity studies of two mangrove associated lichens, Dirinaria consimilis and Ramalina leiodea extracts. Hyg J Drugs Med 2018;10:16-26. [CrossRef]
21. Ahmed S, Roy S, Tayung K, Yasmin F. Assessment of antibacterial potential of different solvent extract of foliose lichens against human pathogenic bacteria. J Appl Pharm Sci 2020;10:72-6.
22. Shendge AK, Panja S, Mandal N. Tropical lichen, Dirinaria consimilis, induces ROS-mediated activation of MAPKs and triggers caspase cascade mediated apoptosis in brain and cervical cancer cells. Mol Cell Biochem 2021;476:2181-92. [CrossRef]
23. Dawoud TM, Alharbi NS, Theruvinthalakal AM, Thekkangil A, Kadaikunnan S, Khaled JM, et al. Characterization and antifungal activity of the yellow pigment produced by a Bacillus sp. DBS4 isolated from the lichen Dirinaria agealita. Saudi J Biol Sci 2020;27:1403-11. [CrossRef]
24. Huynh BL, Le DH, Takenaka Y, Tanahashi T, Nguyen KP. New phenolic compounds from the lichen Parmotrema praesorediosum (Nyl.) Hale (Parmeliaceae). Magn Reson Chem 2016;54:81-7. [CrossRef]
25. Anupama TV, Sheela KB, Suman KT. Elemental composition of edible lichen Parmotrema tinctorum (Nyl.) Hale (Parmeliaceae) from Wayanad. Progress Hortic 2020;52:88-92. [CrossRef]
26. Kusmoro J, Noer IS, Jatnika MF, Permatasari RE, Partasasmita R. Lichen diversity in geothermal area of Kamojang, Bandung, West Java, Indonesia and its potential for medicines and dyes. Biodivers J Biol Divers 2018;19:2335-43. [CrossRef]
27. Saha S, Pal A, Paul S. A review on pharmacological, anti-oxidant activities and phytochemical constituents of a novel lichen Parmotrema species. J Biol Active Prod Nat 2021;11:190-203. [CrossRef]
28. Huynh BL, Duong TH, Do TM, Pinnock TG, Pratt LM, Yamamoto S, et al. New g-lactone carboxylic acids from the lichen Parmotrema praesorediosum (Nyl.) hale, parmeliaceae. Records Nat Prod 2016;10:332.
29. Huynh BL, Pham NK, Nguyen TP. Vinapraesorediosic acids D and E from the lichen Parmotrema praesorediosum (Nyl.) Hale. Phytochem Lett 2020;41:61-4. [CrossRef]
30. Huynh BL, Bui VM, Nguyen KP, Pham NK, Nguyen TP. Three new diphenyl ethers from the lichen Parmotrema praesorediosum (Nyl.) Hale (Parmeliaceae). Nat Prod Res 2022;36:1934-40. [CrossRef]
31. Mohammadi M, Zambare V, Malek L, Gottardo C, Suntres Z, Christopher L. Lichenochemicals:Extraction, purification, characterization, and application as potential anticancer agents. Expert Opin Drug Discov 2020;15:575-601. [CrossRef]
32. Ahmed KS, Ahmed SS, Thangakumar A, Krishnaveni R. Therapeutic effect of Parmotrema tinctorum against complete Freund's adjuvant-induced arthritis in rats and identification of novel Isophthalic ester derivative. Biomed Pharmacother 2019;112:1-11. [CrossRef]
33. Alqahtani MA, Al Othman MR, Mohammed AE. Bio fabrication of silver nanoparticles with antibacterial and cytotoxic abilities using lichens. Sci Rep 2020;10:1-7. [CrossRef]
34. Khandel P, Shahi S, Kanwar L, Yadaw RK, Soni DK. Biochemical profiling of microbes inhibiting silver nanoparticles using symbiotic organisms. Int J Nano Dimens 2018;9:273-85.
35. Awasthi DD. Compendium of the macrolichens from India, Nepal and Sri Lanka. Dehradun:Bishen Singh Mahendra Pal Singh;2007.
36. Widodo H, Sismindari S, Asmara W, Rohman A. Antioxidant activity, total phenolic and flavonoid contents of selected medicinal plants used for liver diseases and its classification with chemometrics. J App Pharm Sci 2019;9:99-105. [CrossRef]
37. Rafi M, Febriany S, Wulandari P, Suparto IH, Ridwan T, Rahayu S, et al. Total phenolics, flavonoids, and anthocyanin contents of six Vireya rhododendron from Indonesia and evaluation of their antioxidant activities. J App Pharm Sci 2018;8:49-54. [CrossRef]
38. Sembiring EN, Elya B, Sauriasari R. Phytochemical screening, total flavonoid and total phenolic content and antioxidant activity of different parts of Caesalpinia bonduc (L.) Roxb. Pharmacogn J 2018;10:123-7. [CrossRef]
39. Shaikh JR, Patil MK. Qualitative tests for preliminary phytochemical screening:An overview. Int J Chem Stud 2020;8:603-8. [CrossRef]
40. Ariffin MM, Khong HY, Nyokat N, Liew GM, Hamzah AS, Boonpisuttinant K. In vitro antibacterial, antioxidant, and cytotoxicity evaluations of Musa paradisiaca cv. Sekaki florets from Sarawak, Malaysia. MPC J Appl Pharm Sci 2021;11:91-9.
41. Missoun F, de los Ríos AP, Ortiz-Martínez V, Salar-García MJ, Hernández-Fernández J, Hernández-Fernández FJ. Discovering low toxicity ionic liquids for Saccharomyces cerevisiae by using the agar well diffusion test. Processes 2020;8:1-18. [CrossRef]
42. Ahamed AA, Rasheed MU, Noorani KP, Reehana N, Santhoshkumar S, Imran YM, et al. In vitro antibacterial activity of MGDG-palmitoyl from Oscillatoria acuminata NTAPC05 against extended-spectrum b-lactamase producers. J Antibiot 2017;70:754-62. [CrossRef]
43. Vora J, Srivastava A, Modi H. Antibacterial and antioxidant strategies for acne treatment through plant extracts. Inform Med Unlocked 2018;13:128-32. [CrossRef]
44. Sethi S, Joshi A, Arora B, Bhowmik A, Sharma RR, Kumar P. Significance of FRAP, DPPH, and CUPRAC assays for antioxidant activity determination in apple fruit extracts. Eur Food Res Technol 2020;246:591-8. [CrossRef]
45. Meher RK, Pragyandipta P, Pedapati RK, Nagireddy PK, Kantevari S, Nayek AK, et al. Rational design of novel N?alkyl amine analogues of noscapine, their chemical synthesis and cellular activity as potent anticancer agents. Chem Biol Drug Des 2021;98:445-65. [CrossRef]
46. Meher RK, Nagireddy PK, Pragyandipta P, Kantevari S, Singh SK, Kumar V, et al. In silico design of novel tubulin binding 9-arylimino derivatives of noscapine, their chemical synthesis and cellular activity as potent anticancer agents against breast cancer. J Biomol Struct Dyn 2021;39:1-12. [CrossRef]
47. Meher RK, Pragyandipta P, Reddy PK, Pedaparti R, Kantevari S, Naik PK, et al. Development of 1,3-diynyl derivatives of noscapine as potent tubulin binding anticancer agents for the management of breast cancer. J Biomol Struct Dyn 2021;39:1-18. [CrossRef]
48. LicáIC, Soares AM, de Mesquita LS, Malik S. Biological properties and pharmacological potential of plant exudates. Food Res Int 2018;105:1039-53. [CrossRef]
49. Ashokkumar K, Murugan M, Dhanya MK, Warkentin TD. Botany, traditional uses, phytochemistry and biological activities of cardamom [Elettaria cardamomum (L.) Maton] a critical review. J Ethnopharmacol 2020;246:112244. [CrossRef]
50. Costa DC, Costa HS, Albuquerque TG, Ramos F, Castilho MC, Sanches-Silva A. Advances in phenolic compounds analysis of aromatic plants and their potential applications. Trends Food Sci Technol 2015;45:336-54. [CrossRef]
51. Soto-Hernández M, Tenango MP, García-Mateos R. Phenolic Compounds:Natural Sources, Importance and Applications. Norderstedt. BoD-Books on Demand;2017.
52. Albuquerque BR, Heleno SA, Oliveira MB, Barros L, Ferreira IC. Phenolic compounds:Current industrial applications, limitations and future challenges. Food Funct 2021;12:14-29. [CrossRef]
53. Tanase C, Co?arc?S, Muntean DL. A critical review of phenolic compounds extracted from the bark of woody vascular plants and their potential biological activity. Molecules 2019;24:1182. [CrossRef]
54. Cosme P, Rodríguez AB, Espino J, Garrido M. Plant phenolics:Bioavailability as a key determinant of their potential health-promoting applications. Antioxidants (Basel) 2020;9:1263. [CrossRef]
55. Murugesan P. Phytochemical analysis and antimicrobial activity of edible lichen. J Drug Deliv Ther 2020;10:102-4. [CrossRef]
56. Moghimipour E, Handali S. Saponin:Properties, methods of evaluation and applications. Ann Res Rev Biol 2015;207-20. [CrossRef]
57. Sharma P, Tyagi A, Bhansali P, Pareek S, Singh V, Ilyas A, et al. Saponins:Extraction, bio-medicinal properties and way forward to anti-viral representatives. Food Chem Toxicol 2021;1-14. [CrossRef]
58. Nadaraia NS, Amiranashvili LS, Merlani M, Kakhabrishvili ML, Barbakadze NN, Geronikaki A, et al. Novel antimicrobial agents'discovery among the steroid derivatives. Steroids 2019;144:52-65. [CrossRef]
59. Omar F, Tareq AM, Alqahtani AM, Dhama K, Sayeed MA, Emran TB, et al. Plant-based indole alkaloids:A comprehensive overview from a pharmacological perspective. Molecules 2021;26:1-26. [CrossRef]
60. Ullah F, Iqbal N, Ayaz M, Sadiq A, Ullah I, Ahmad S, et al. DPPH, ABTS free radical scavenging, antibacterial and phytochemical evaluation of crude methanolic extract and subsequent fractions of Chenopodium botrys aerial parts. Pakistan J Pharm Sci 2017;30:761-6.
61. Bowyer MC, Van Vuong Q, Van Altena IA, Scarlett CJ. Phytochemicals and antioxidant capacity of Xao tam phan (Paramignya trimera) root as affected by various solvents and extraction methods. Ind Crops Prod 2015;67:192-200. [CrossRef]
62. Truong DH, Nguyen DH, Ta NT, Bui AV, Do TH, Nguyen HC. Evaluation of the use of different solvents for phytochemical constituents, antioxidants, and in vitro anti-inflammatory activities of Severinia buxifolia. J Food Qual 2019;2019:8178294. [CrossRef]
63. Kumari P, Khatkar BS, Duhan A. Aonla phytochemicals:Extraction, identification and quantification. J Food Sci Technol 2019;56:2278-86. [CrossRef]
64. El?Hadary AE, Taha M. Pomegranate peel methanolic?extract improves the shelf?life of edible?oils under accelerated oxidation conditions. Food Sci Nutr 2020;8:1798-811. [CrossRef]
65. El-Garawani I, Emam M, Elkhateeb W, El-Seedi H, Khalifa S, Oshiba S, et al. In vitro antigenotoxic, antihelminthic and antioxidant potentials based on the extracted metabolites from lichen, Candelariella vitellina. Pharmaceutics 2020;12:1-22. [CrossRef]
66. Vivek MN, Kambar Y, Manasa M, Kekuda TR, Vinayaka KS. Radical scavenging and antibacterial activity of three Parmotrema species from Western Ghats of Karnataka, India. J App Pharm Sci 2014;4:86. [CrossRef]
67. Rajan VP, Gunasekaran S, Ramanathan S, Murugaiyah V, Samsudin MW, Din LB. Biological activities of four Parmotrema species of Malaysian origin and their chemical constituents. J Appl Pharm Sci 2016;6:36-43. [CrossRef]
68. Aryal S, Baniya MK, Danekhu K, Kunwar P, Gurung R, Koirala N. Total phenolic content, flavonoid content and antioxidant potential of wild vegetables from Western Nepal. Plants 2019;8:96. [CrossRef]
69. Amri FS, Hossain MA. Comparison of total phenols, flavonoids and antioxidant potential of local and imported ripe bananas. Egypt J Basic Appl Sci 2018;5:245-51. [CrossRef]
70. Shen N, Wang T, Gan Q, Liu S, Wang L, Jin B. Plant flavonoids:Classification, distribution, biosynthesis, and antioxidant activity. Food Chem 2022;383:132531. [CrossRef]
71. Ji M, Gong X, Li X, Wang C, Li M. Advanced research on the antioxidant activity and mechanism of polyphenols from Hippophae species a review. Molecules 2020;25:917. [CrossRef]
72. Behiry SI, Okla MK, Alamri SA, El-Hefny M, Salem MZ, Alaraidh IA, et al. Antifungal and antibacterial activities of Musa paradisiaca L. peel extract:HPLC analysis of phenolic and flavonoid contents. Processes 2019;7:215. [CrossRef]
73. Dhawan D, Gupta J. Research article comparison of different solvents for phytochemical extraction potential from Datura metel plant leaves. Int J Biol Chem 2017;11:17-22. [CrossRef]
74. Mai-Prochnow A, Clauson M, Hong J, Murphy AB. Gram positive and Gram-negative bacteria differ in their sensitivity to cold plasma. Sci Rep 2016;6:1-11. [CrossRef]
75. Papuc C, Goran GV, Predescu CN, Nicorescu V, Stefan G. Plant polyphenols as antioxidant and antibacterial agents for shelf?life extension of meat and meat products:Classification, structures, sources, and action mechanisms. Comp Rev Food Sci Food Saf 2017;16:1243-68. [CrossRef]
76. Othman L, Sleiman A, Abdel-Massih RM. Antimicrobial activity of polyphenols and alkaloids in middle eastern plants. Front Microbiol 2019;10:911. [CrossRef]
77. Górniak I, Bartoszewski R, Króliczewski J. Comprehensive review of antimicrobial activities of plant flavonoids. Phytochem Rev 2019;18:241-72. [CrossRef]
78. Ganesan A, Purushothaman DK, Muralitharan U, Subbaiyan R. Metabolite profiling and in vitro assessment of antimicrobial and antioxidant activities of lichen Ramalina inflata. Int Res J Pharm 2017;7:132-8. [CrossRef]
79. Plaza CM, Salazar CP, Plaza RE, Vizcaya M, Rodriguez-Castillo G, Medina-Ramirez G. In vitro analysis of antibacterial and antifungal potential of lichen species of Everniastrumcf vexans, Parmotrema blanquetianum, Parmotrema reticulatum and Peltigera laciniata. MOJ Drug Des Dev Ther 2018;2:125-34. [CrossRef]
80. Azman AA, Nadiah N, Rosandy AR, Alwi A, Kamal N, Mohd R. Antimicrobial activity and LC-MS data comparison from lichen Parmotrema praesorediosum in Bangi, Selangor, Malaysia. Sains Malays 2021;50:383-93. [CrossRef]
81. World Health Organization. Global Cancer Observatory. Geneva:International Agency for Research on Cancer, World Health Organization;2020. Available from:http://gco.iarc.fr. [Last accessed on 2021 Sep 05].
82. Londoño-Castañeda PA, Buril ML, Rego-Cunha IP, Silva NH, Honda NK, Pereira EC, et al. Lichens used in the traditional medicine by the Pankararu indigenous community, Pernambuco-Brazil. Glob J Sci Front Res 2017;17:15-22.
83. Tatipamula VB, Nguyen HT, Kukavica B. Beneficial effects of liposomal formulations of lichen substances:A review. Curr Drug Del 2022;19:252-9. [CrossRef]
84. Shendge AK, Panja S, Basu T, Mandal N. A tropical lichen, Dirinaria consimilis selectively induces apoptosis in MCF-7 cells through the regulation of p53 and caspase-cascade pathway. Anticancer Agents Med Chem 2020;20:1173-87. [CrossRef]